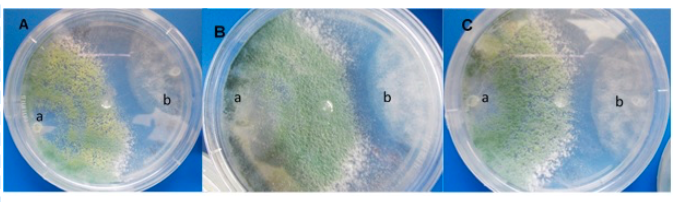

Introducción
El cultivo de chile (Capsicum annuum L.) en México, enfrenta graves problemas fitosanitarios que limitan su producción a causa de enfermedades como la marchitez del chile, inducida por un complejo de fitopatógenos de suelo, entre ellos Phytophthora capsici Leo (Hernández-Castillo et al., 2014), Rhizoctonia solani Kühn y Fusarium oxysporum (Vásquez et al., 2009). Los principales síntomas que provoca esta enfermedad son la muerte prematura de las plantas al causar la obstrucción y desequilibrio del funcionamiento de los haces vasculares, defoliación, cambios de color, rizado del follaje, daño a estructuras reproductivas, maduración adelantada e irregular, pudrición de la raíz, necrosis del tallo y ocurrencia de rebrotes (Granke et al., 2012, Rivera et al., 2018).
Para controlar la incidencia y severidad de estos patógenos, se utilizan fungicidas altamente tóxicos y residuales que provocan un impacto ambiental negativo, contaminando el suelo, el aire y los mantos acuíferos, además intoxican al ser humano, crean resistencia genética en los fitopatógenos a los ingredientes activos (Matar et al., 2009; Osorio et al., 2016; Hernández-Hernández et al., 2018) e incrementan los costos de producción. Otra consecuencia es la reducción del área de siembra debido a la infestación del suelo es el aumento en la severidad e incidencia de la enfermedad y reducción de los rendimientos obtenidos por superficie sembrada (García, 2010).
La relevancia del género Trichoderma radica en la eficiencia que posee para combatir enfermedades, se ha reportado en múltiples estudios el impacto que tiene sobre las pudriciones de raíz, problemática que se encuentra entre las enfermedades que causan pérdidas económicas significativas en diferentes cultivos agrícolas. Aunque los productos químicos son aún la principal herramienta de control para estas enfermedades, los agentes biológicos son una manera efectiva para proporcionar un control más rápido y más seguro (Verma et al., 2007).
Se ha investigado durante más de 70 años los mecanismos de control biológico de las especies de Trichoderma spp. (Martínez et al., 2013), su capacidad antagónica está ampliamente documentada como agentes de biocontrol de diversos patógenos que afectan cultivos de importancia agrícola y económica (Infante et al., 2009; Mayo et al., 2015). Las cepas de Trichoderma producen enzimas extracelulares (Osorio-Hernández et al., 2016), compiten con los hongos patógenos por espacio y nutrientes al reducir o detener completamente el desarrollo del fitopatógeno (Sánchez-García et al., 2017), promueven el crecimiento de las plantas e inducen resistencia sistémica, micoparasitismo y antibiosis mediante acción restrictiva directa a los hongos fitopatógenos.
Estos mecanismos se ven favorecidos por la habilidad de los aislamientos de Trichoderma para colonizar la rizósfera de las plantas. (Leandro et al., 2007; Woo y Lorito, 2007; Guédez et al., 2012). Las diferentes especies de Trichoderma son una alternativa para el biocontrol contra diversos fitopatógenos de suelo (Singh et al., 2011) entre ellos P. capsici, F. oxysporum y R. solani, además de estimular el incremento de la biomasa radicular y el área foliar (Ezziyyani et al., 2005; Ezziyyani et al., 2007). Por lo anterior, el objetivo de la presente investigación fue determinar el efecto antagónico de Trichoderma spp., como método de biocontrol para el complejo de fitopatógenos que causan marchitez del chile en evaluaciones in vitro mediante cultivos duales.
Materiales y métodos
Ubicación del estudio
El presente trabajo se llevó a cabo en el Laboratorio de Biología de la Universidad Intercultural del Estado de Puebla, Huehuetla, Puebla, México. Sus coordenadas geográficas son los paralelos 20º 01’ 48” y 20º 09’ 12” de latitud norte y los meridianos 97º 35’ 00” y 97º 40’ 24” de longitud oeste.
Material fúngico
Se aislaron de suelo tres especies de Trichoderma en medio papa dextrosa-agar (PDA). Se dispersó 1 g de suelo húmedo en cajas con medio PDA y se incubaron a 25 ±2 °C en oscuridad durante dos días, después se retiraron de la incubadora y se mantuvieron bajo lámpara de luz blanca por dos días para inducir esporulación de Trichoderma sp., del desarrollo de Trichoderma, se tomó una porción para transferir a medio de cultivo PDA e incubar a 25 ±2 °C, esto se realizó hasta obtener crecimientos axénicos y puros, libres de otros hongos o bacterias. Después de la última esporulación en este medio, se conservaron en agua estéril y aceite mineral.
Los patógenos Rhizoctonia sp., Fusarium sp. y Phytophthora capsici se aislaron de raíces de chile, las raíces se lavaron con agua corriente; posteriormente, la porción de tejido se desinfestó por inmersión durante 1 min en solución 1.5% de hipoclorito de sodio y se enjuagó con agua destilada estéril, las raíces se escurrieron sobre sanitas estériles, finalmente se sembraron fragmentos de 1 cm en medio PDA para el aislamiento y purificación de Rhizoctonia sp. y Fusarium sp.
En el caso del oomicete Phytophthora capsici se sembraron raíces de chile de 1.5 cm de longitud en medio agar-agar® con jugo-V8® (jugo de 8 verduras) y se adicionaron antibióticos (Pimaricina 10 µg L-l, Ampicilina 292 µg L-1, Rifampicina 10 µg L-1, Pentacloronitrobenceno 0.1 g L-1 e Himexazol 0-25 µg L-1), posteriormente se incubaron a 28 ±2 °C durante tres días (Andrade et al., 2012), previamente purificados los patógenos de la raíz del chile se mantuvieron bajo conservación en agua estéril con el fin de preservación (Molina-Gayosso et al., 2016). Previó a la confrontación dual los microorganismos se activaron en medio de cultivo PDA más ácido láctico (Figura 1).
Caracterización morfológica
Para estudiar las características morfológicas, tanto los aislamientos de los patógenos como de Trichoderma, se cultivaron en medio PDA y se incubaron a 24 ±2 °C durante 12 h bajo luz blanca (Rivera-Jiménez et al., 2018). En la identificación del género Fusarium sp. se utilizó como referencia la descripción de Burgess et al. (1994) y la identificación de la especie se realizó mediante las claves de Seifert (1996). La identificación de la especie de Rhizoctonia se realizó con base en Sneh et al. (1991) y la del oomicete Phytophthora sp. se caracterizó mediante las claves de Erwin y Ribeiro (1996); de Gallegly y Hong (2008).
Por último, en la caracterización morfológica de los aislamientos de Trichoderma spp. se utilizaron las claves taxonómicas de Barnett y Hunter (1972). Para los aislamientos de Trichoderma se utilizaron cultivos monoconidiales en combinación con la técnica de cámara húmeda (Harris, 1986). Un disco de PDA de 5 mm de diámetro se inoculó con la espora de Trichoderma y se colocó entre un porta y cubreobjetos y esta preparación sobre un triángulo de varilla estéril dentro de una caja petri y se incubó a 25 ±2 °C durante 24 h.
Las características macro y microscópicas a considerar fueron textura de la colonia, presencia de micelio, anillos concéntricos, tinción de la colonia al reverso, forma y tamaño de conidios y fiálides (Chaverri et al., 2015; Jang et al., 2018; Nawaz et al., 2018; Du Plessis et al., 2018), se observaron las estructuras de los aislamientos de Trichoderma spp. a 40X en un microscopio óptico (Zeiss Axiosiop plus).
Tasa de crecimiento
En la determinación de la tasa de crecimiento de micelio en antagonistas y patógenos, crecidos en PDA, se realizaron mediciones cada ocho horas.
Actividad antagónica de Trichoderma sobre patógenos
La técnica de cultivos duales se empleó para determinar la actividad antagónica de los diferentes aislamientos de Trichoderma sobre Rhizoctonia sp., Fusarium sp. y P. capsici (Sonnenbichler et al., 1983). Se empleó un diseño completamente aleatorizado (con dos factores: Trichoderma y los patógenos), con ocho repeticiones.
Los ensayos se realizaron evaluando cultivos duales de Trichoderma spp., contrapuestos con tres fitopatógenos, tres aislamientos de Trichoderma contra Rhizoctonia sp., Fusarium sp. y P. capsici. En la prueba de cultivos duales se utilizaron cajas petri con PDA libre de antibióticos, se depositó en un extremo un disco de 5 mm de diámetro con micelio activo del fitopatógeno (previamente crecido en PDA por cinco días) y en el extremo equidistante se colocó un disco de micelio (previamente crecido en PDA por cinco días) de 5 mm de diámetro con Trichoderma spp., las cajas se incubaron a 28 ±2 ºC y se observaron cada 8 h para registrar el número de días al primer contacto entre el antagonista y el fitopatógeno, se midió el crecimiento de ambas colonias (cm) y se evaluó el porcentaje de inhibición del crecimiento micelial radial, basándose en la fórmula propuesta por Ezziyyani et al. (2007), calculando de la siguiente manera:
Donde: PICR= porcentaje de inhibición de crecimiento radial; R1= crecimiento radial (mm) del patógeno sin Trichoderma spp., R2= crecimiento radial (mm) del patógeno con Trichoderma spp.
Micoparasitismo de Trichoderma sobre patógenos
Para conocer la presencia de parasitismo de las cepas de Trichoderma hacia Rizoctonia sp., Fusarium sp. y P. capsici se empleó la técnica de microcultivos de Riddel descrita por Paul (1999). Esta técnica consiste en colocar dentro de una caja de petri una varilla de vidrio en forma de V y sobre ella, un portaobjetos estéril, sobre el cual se dispuso un disco de PDA de 10 mm de diámetro. La disposición de cada hongo se realizó en dos puntos cardinales, después de colocar el micelio de ambos hongos sobre el PDA, con una diferencia de 24 h, primero se colocaron los patógenos con ayuda de una aguja estéril, los cuales tienen un crecimiento lento comparado con Trichoderma y se colocó un cubreobjetos estéril, se incubó a 25 ±2 °C.
Cuando el disco de agar fue cubierto con el crecimiento de ambos hongos, el portaobjetos fue retirado de la caja de petri para preparar los frotis. El cubreobjetos fue colocado en otro portaobjeto limpio y provisto de una gota de colorante conocido como azul de algodón. Por otro lado, se retiró el disco de agar del portaobjetos original, se colocó una gota del colorante y un cubreobjetos. Una vez eliminado el exceso de colorante, las preparaciones fueron selladas y evaluadas microscópicamente, es decir se observaron 10 muestras para determinar si hubo o no parasitismo por las cepas de Trichoderma sp., se observó a 40X en un microscopio óptico (Zeiss Axiosiop plus).
Análisis estadístico
Los datos del PICR, expresados en porcentaje, se transformaron con el angular arcoseno √x+1 (Steel et al., 1986) y en el crecimiento micelial en la prueba de biocontrol, se utilizó un diseño completamente aleatorizado (tres cepas de Trichoderma sp. y tres fitopatógenos) con ocho repeticiones. Los datos obtenidos para cada uno de los ensayos se sometieron a un análisis de varianza y una prueba de comparación de medias Tukey (p≤ 0.05). Dichos datos se analizaron con el paquete estadístico SAS versión 9.0 para Windows (SAS, 2002).
Resultados y discusión
Caracterización morfológica
Los patógenos causantes de la marchitez del chile correspondieron con lo reportado por Rivera-Jiménez et al. (2018). Se encontró similitud con F. oxysporum, las colonias de crecimiento en PDA tenían abundante micelio aéreo y de color rosa pálido a morado intenso a color magenta con una textura algodonosa. Los macro-conidios presentaron de uno a cinco septos, los conidios midieron 23-54 × 3-4.5 μm, respectivamente. En la identificación de Rhizoctonia solani correspondió con lo reportado por Sneh et al. (1991) y Lozano et al. (2015), R. solani se caracterizó por formar micelio aéreo, color marrón, en medio de cultivo PDA formo micelio hialino.
Las hifas generalmente mostraron un ángulo recto y después de este se formó un septo, los diámetros de las hifas presentaron de 4.1 a 8.9 μm, lo que corresponde con Barnett y Hunter (1998). El aislamiento de Phytophthora capsici se caracterizó por formar esporangios ovoides, elongados, elipsoides con una o dos papilas, el tamaño de los esporangios fue de 35.8 a 64.7 x 19.6 a 25.2 μm., finalmente e grosor apical fue de 1.85 a 4.3 μm (Erwin y Ribeiro, 1996; Gallegly y Hong, 2008).
De acuerdo con los criterios de identificación taxonómica de Barnett y Hunter (1972), las especies de Trichoderma se compararon con claves taxonómicas e identificadas por sus características morfológicas. Las especies de T. harzianum presentaron colonias color verde claro a oscuro con textura polvosa a algodonosa, con micelio, conidióforo y conidios de aspecto de color verde (Figura 2, Cuadro 1) muestran diversas ramificaciones en forma piramidal, en algunos casos se observa la formación de dos a tres ramas laterales y presenta micelio aéreo. En T. asperellum y T. viride se aprecia una coloración ausente al reverso de la placa petri.

Figura 2 Tasa de crecimiento, a) T. harzianum, T. viride y T. asperellum; y b) P. capsici, R. solani y F. oxysporum.
Cuadro 1 Caracterización morfológica de Trichoderma spp.
| Trichoderma spp. | Color de colonia | Textura de colonia | Micelio aéreo | Anillos | Color al reverso | Forma de conidios | Tamaño conidios (μm) | Forma fiálides | Tamaño fiálides (μm) |
| T. harzianum | Verde oscuro a color grisáceo | Algodonosa | Abundante | Sin presencia | Incoloro | Subgloboso | 3.8-4 x 3.1-3.7 | Globosa | 6.3-15.6 x 2.7-3.4 |
| T. asperrellum | verde claro a verde oscuro | Polvoso | Sin presencia | de 3 a 4 anillos | Incoloro | Ovoide a elisoipde | 4-4.4 x 3-3.5 | Ligeramente globoso | 2.3-2.8 x10.2-11.8 |
| T. viride | Verde oscuro | Algodonosa | Abundante | Sin presencia | Incoloro | Globoso Elipsoidal | 4-4.8 x3.5-4 | Lageniformes | 8-14 x2.4-3 |
Las esporas y fiálides, estructuras características corresponden a especies de Trichoderma, presentaron formas y tañamos característicos de las especies de T. harzianum, T. asperellum y T. viride correspondiente a lo reportado por diferentes autores (Barnett et al., 1972; de Hoog, 2000; Romero-Arenas et al., 2009; Chaverri et al., 2015; Jaklitsch et al., 2015).
Tasa de crecimiento
La evaluación de la tasa de crecimiento inicial de los antagonistas y patógenos resultaron estar completamente relacionadas al iniciar crecimiento del micelio a las 8 h; sin embargo, las tres especies de Trichoderma tienen la capacidad de antagonismo por completar el llenado de la caja petri en 80 h. Estos resultados indica la importancia de conocer la velocidad de crecimiento de los patógenos, así como de los antagonistas de T. harzianum, T. viride y T. asperellum.
Los aislamientos de Trichoderma spp., mostraron un crecimiento más rápido que los patógenos, este comportamiento es promisorio en el control de patógenos de la raíz, además permitió este ensayo permitió considerarlo para las pruebas de PICR y dar ventaja de dos días a Fusarium oxysporum, Rhizoctonia solani y Phytophthora capsici.
Actividad antagónica de Trichoderma sobre patógenos
La actividad antagónica de T. viride contra P. capsici mostró diferencia significativa (p≤ 0.05), debido a que T. viride presentó 0.516 mm en comparación de P. capsici que obtuvo 0.241 mm de crecimiento en caja petri con medio de cultivo; es decir, T. viride puede utilizarse como agente de control biológico, por ser eficaz contra P. capsici, ya que también se observó hiperparasitismo por parte del patógeno (Figura 3). Lo anterior, concuerda con lo reportado por Bouziane et al. (2016), al evaluar a T. viride contra P. infestans en pruebas in vitro, encontraron que el hongo benéfico mostró capacidad inhibitoria entre 58 y 68%, resultados similares fueron al evaluar en plantas.
Figura 3 Crecimiento dual, confrontamientos in vitro con Trichoderma en contra de los patógenos, A) Trichoderma viride vs P. capsici; B) Trichoderma asperellum vs Fusarium oxysporum; y C) Trichoderma harzianum vs Rhizoctonia solani.
De igual forma, Zegeye et al. (2011), encontraron que T. viride mostró una inhibición completa en el crecimiento radial de P. infestans en pruebas in vitro. Además, mencionaron que la aplicación foliar de T. viride tiene un buen potencial para controlar a P. infestans en condiciones de invernadero. Por otra parte, la evaluación de antagonismo dual de T. viride contra F. oxysporum presentaron crecimiento de 0.656 mm del antagonista y 0.221 mm por parte del patógeno, esto evidencia como T. viride es apto para la utilización en el control de F. oxysporum.
En la confrontación dual T. viride contra R. solani obtuvieron un crecimiento del antagonista de 0.746 mm y del patógeno 0.112 mm, los resultados de crecimiento por parte del antagonista fueron mayor en comparación con el patógeno (Figura 3). En ambos casos se han encontrado resultados similares donde los dos hongos son micoparasitados o destruidos por T. viride (Figura 3) ya que tiene un efecto antifúngico con este patógeno (Jhon et al., 2010; Perveen, 2012; Sánchez-García et al., 2017).
Es importante mencionar, que en las primeras 8 h el crecimiento de los antagonistas mostraron un crecimiento acelerado que propicia el encuentro con el patógeno en menor tiempo, indicativo que el antagonista creció o cubrió más superficie en cultivo in vitro.
Resultados similares mencionaron diversos autores donde demostraron que Trichoderma spp y T. viride son utilizados para el control biológico de R. solani (Sánchez-García et al., 2017). Se observó un efecto antifúngico, en el que inhibe el crecimiento y causa lisis a este patógeno. En las confrontaciones de T. viride contra los agentes causantes de la marchitez del chile. La evaluación del antagonismo de T. harzianum contra P. capsici, F. oxysporum y R. solani (Figura 4) presentó mayor crecimiento por parte del antagonista en comparación con el patógeno, denotando hiperparasitismo al invadir completamente al patógeno, resultado similar obtuvo Osorio-Hernández et al. (2011) en el que observó que Tricoderma spp., es un antagonista eficaz para el control de P. capsici, inhibiendo este patógeno hasta 48%.

Figura 4 Crecimiento micelial (mm) en la prueba de biocontrol de A) T. viride vs P. capsici, F. oxysporum y R. solani; B) T. asperellum. Vs P. capsici, F. oxysporum y R. solani; y C) T. harzianum vs P. capsici, F. oxysporum y R. solani.
Asimismo, en la confrontación de T. viride en contra de F. oxysporum y R. solani, se encontró la misma tendencia. Se encontró un valor significativo (p≤ 0.05) en la evaluación de susceptibilidad con base al PICR de los tres patógenos responsables de la marchitez del chile; sin embargo, la mayor susceptibilidad la presentó Fusarium oxysporum con 92.68%, seguido de Rizoctonia solani y P. capsici (Cuadro 2), resultados que prueban la eficacia de los antagonistas (Osorio et al., 2016) ante patógenos que afectan la raíz del chile desde plántulas y plantas en producción (Romero et al., 2017).
Cuadro 2 Evaluación de la susceptibilidad de los patógenos ante Trichoderma y porcentaje de inhibición de Trichoderma sp. contra los patógenos causantes de la marchitez del chile.
| Patógenos | Susceptibilidad de patógenos ante Trichoderma PICR (%) | Trichoderma | Actividad antagónica Trichoderma PICR (%) |
| Fusarium oxysporum | 92.68 a | T. asperellum | 88.25 a |
| Rhizoctonia solani | 87.86 b | T. viride | 87.22 a |
| Phytophthora capsici | 83.33 c | T. harzianum | 87.8 a |
a, b, c= denota los tratamientos medios que son significativamente iguales o diferentes según la prueba de Tukey en p< 0.05. PICR = porcentaje de inhibición de crecimiento radial.
En la valoración del porcentaje de inhibición de crecimiento radial (PICR) de los patógenos causantes de la marchitez del chile no hubo diferencias significativas entre los antagonistas T. asperellum, T. viride y T. harzianum; por lo que se sugiere utilizar como agente de control biológico cualquiera de los tres Trichoderma; es decir, son efectivo por inhibir más de 85% a los patógenos causantes de la marchitez del chile (Cuadro 2), la respuesta de inhibición del crecimiento de fitopatógenos es debido a la síntesis de metabolitos secundarios y a los diferentes mecanismos de acción de micoparasitismo (Harman, 2006; Infante, 2009).
El comportamiento similar de inhibición de los tres tratamientos son favorables resultados enontrados por quienes reportan que por arriba de 80% de inhibición es aceptable en el biocontrol de patógenos que se transmiten por el suelo y por la eficacia de combatir enfermedades de la raíz (Hermosa et al., 2012; Sabbagh et al., 2017).
Los resultados de micoparasitismo de los antagonistas con frecuencia tuvo un crecimiento más favorable, cabe mencionar que las primeras 8 h fueron significativas (p≤ 0.05) mostrando que el antagonista tuvo un crecimiento acelerado que propicia que el encuentro se pueda tener en un tiempo corto. Asimismo, se pudo observar que no solo presentó la inhibición del crecimiento de estos patógenos, sino que también presentó una invasión (hiperparasitismo) total del antagonista hacia el patógeno inclusive esporulando sobre el patógeno. En un estudio con selecciones de 25 cepas de Trichoderma entre ellas T. harzianum, de las cuales presentaron inhibición en F. oxysporum sobre el crecimiento de micelio en 33 y 35%.
De igual manera, Sinuco et al. (2017) indican que los compuestos orgánicos volátiles de T. viride afectaron los halos de crecimiento de Fusarium spp. El crecimiento de T. asperellum mostró diferencias significativas (p≤ 0.05) al confrontarse con los diferentes patógenos causantes de la marchitez del chile causados por los patógenos de P. capsici, F. oxysporum y R. solani (p≤ 0.001) ya que al hacer el análisis de los datos se pudo observar que la tasa de crecimiento del patógeno se redujo prácticamente a la mitad al confrontarse con T. asperellum.
Además, de que este antagonista sobrecreció sobre los patógenos hasta 100%, cubriendo la caja completamente y causando así un hiperparasitismo, mostrando así una capacidad antagónica muy eficiente ante cada uno de los patógenos.
Estos resultados coinciden con otros autores quienes mencionaron que Trichoderma ssp. sobrecrece a Phytophthora causando un hiperparasitismo (Bae et al., 2016). De igual forma, Trichoderma spp. se desarrolla contra R. solani, causando la inhibición del crecimiento in vitro de R. solani de 58 a 86%. Trichoderma spp., tiene la capacidad de inducir la expresión de genes relacionados con la defensa de las plantas y producir un mayor nivel de ergosterol, lo que indica su capacidad de crecer a un ritmo mayor en el suelo, esto explica sus efectos positivos sobre el crecimiento y la defensa de la planta en presencia del patógeno (Mayo et al., 2015).
Los aislamientos de Trichoderma confrontados con P. capsici ejercieron un efecto antagónico altamente significativo (p≤ 0.001), causando la inhibición en el crecimiento del oomiceto en condiciones duales. T. harzianum, T. viride y T. asperellum, también tuvieron un comportamiento similar contra F. Oxysporum y R. solani (Figura 4). Los antagonistas continuaron creciendo hasta seis días después, mostrando hiperparasitismo al invadir o crecer completamente sobre el patógeno. Al respecto, Segarra et al. (2013), mencionaron que T. asperellum cepa T34, es capaz de reducir a P. capsici hasta 71%, al aplicarse en plantas de pimiento en diferentes etapas de crecimiento.
Micoparasitismo
En los ensayos in vitro se evaluó la inhibición de las tres especies de Trichoderma, los resultados mostraron la eficacia en la competencia por espacio y nutrientes, además de apreciar la habilidad parasítica contra Rhizoctonia solani, Fusarium oxysporum y P. capsici. Además, s se observó mediante microscopía de luz y corroborar en los microcultivos y cultivos de doble confrontación en el punto de cruce entre los aislamientos nativos de Trichoderma spp. y patógenos causantes de la marchitez del chile los diferentes tipos de micoparasitismo (Figura 5).

Figura 5 Micoparasitismo de Trichoderma sp. a) T. harzianum rodeando al micelio de Rhizoctonia solani; b) T. viride y T. asperellum rodeando el micelio de P. capsici; y c) enrollamiento masivo de T. asperellum cubriendo a Fusarium oxysporum.
En algunas primeras investigaciones se han observado mico-parasitismo, antibiosis, además de que Trichoderma tiene un comportamiento de crecimiento paralelo al patógeno hasta enrollarlo evitando los diferentes mecanismos de supervivencia del patógeno (Chet et al., 1981; Harman, 2006; Infante, 2009).
Conclusiones
T. asperellum, T. viride y T. harzianum son antagónicos eficientes de los fitopatógenos que causan la marchitez del chile. Las pruebas con estos microorganismos antagonistas han demostrado la existencia de alternativas biológicas para el control de fitopatógenos de la raíz de chile en condiciones de laboratorio, por ello, se sugiere realizar evaluaciones de biocontrol con estos aislamientos y cultivo de chile en invernadero y a campo abierto. Esto coadyuvará para conocer el comportamiento en condiciones de competencia con una diversidad mayor de microorganismos y factores ambientales diferentes a los estudiados.











 texto em
texto em 



